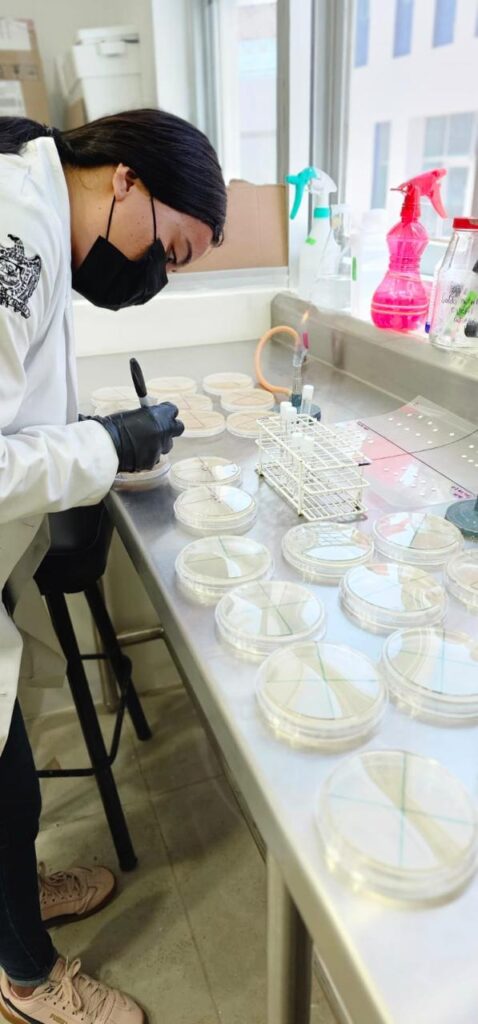

Investigación de la UAZ explora el potencial de los propóleos mexicanos contra una enfermedad desatendida
Zacatecas, Zac., 03 de diciembre de 2025.
La Maestría en Ciencias Biomédicas perteneciente al Área de Ciencias de la Salud (ACS) de la Universidad Autónoma de Zacatecas (UAZ), impulsa un proyecto innovador que estudia el efecto antiparasitario in vitro de propóleos de diferentes regiones de México en larvas tempranas de Toxocara canis, un parásito responsable de la toxocariasis, considerada una de las zoonosis -enfermedades infecciosas- más desatendidas a nivel mundial.
La investigación es dirigida por la docente investigadora, Marisol Galván Valencia, junto con el cuerpo académico CA-UAZ-235 Modelos experimentales para el diagnóstico y la terapéutica, y en codirección de la docente investigadora, María Isabel Chávez Ruvalcaba, del cuerpo académico CA-UAZ-248 Parasitología celular, microbiología e inmunoparasitología.
El objetivo es evaluar la eficacia antihelmíntica del extracto hidroalcohólico de propóleos recolectados en cuatro estados del país, durante las primeras etapas de desarrollo de las larvas infectantes de T. canis.
Se detalla que el propóleo, sustancia natural producida por las abejas, ha sido utilizado desde hace siglos en la medicina tradicional. Hoy, la ciencia confirma sus propiedades antimicrobianas, antiinflamatorias y antioxidantes, lo que lo convierte en un candidato prometedor para enfrentar problemas de salud pública.
La toxocariasis afecta principalmente a niños y se transmite desde animales domésticos al ser humano. Los tratamientos actuales son limitados y poco eficaces, lo que hace urgente explorar alternativas terapéuticas.
Entre los propóleos analizados, el recolectado en Ojocaliente, Zacatecas, ha mostrado resultados especialmente alentadores, ya que contiene altos niveles de flavonoides y compuestos fenólicos, posee gran capacidad antioxidante y ha demostrado actividad contra bacterias como Staphylococcus aureus y Escherichia coli, así como contra el hongo Candida albicans. Estas características refuerzan la expectativa de que pueda tener un efecto antihelmíntico relevante.
Los investigadores destacan que aún queda mucho por descubrir sobre las propiedades del propóleo mexicano. Sin embargo, los avances obtenidos sugieren que podría convertirse en una alternativa o complemento a los tratamientos farmacológicos, contribuyendo a reducir la resistencia a los antibióticos convencionales y ofreciendo nuevas soluciones frente a esta enfermedad olvidada.
Texto y fotos: María Fernanda Galindo R y Marisol Galván Valencia/ Revisión: Pamela Girón.